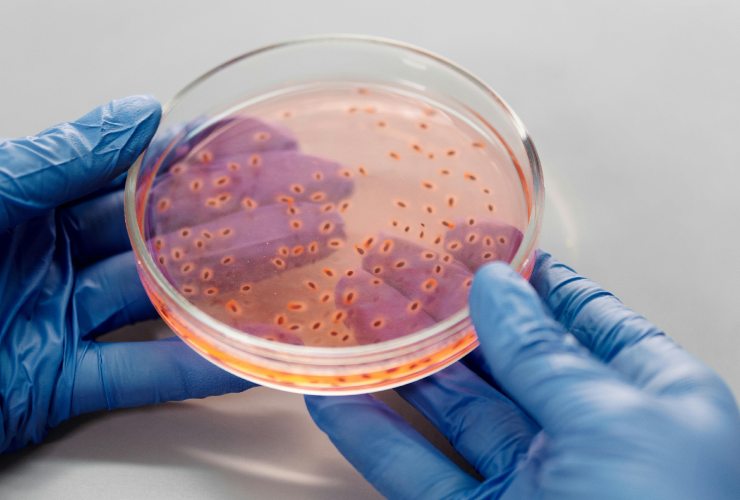

400 volte più batteri dei bagni: lo fai ogni giorno, eppure è disgustoso | Un’abitudine che può farti prendere una malattia

I batteri sono ovunque, ma ci sono dei punti dove i batteri si annidano senza che ne sai nulla. Cosa sta succedendo? (Pexels Foto) - financecue.it
I batteri sono ovunque, ma ci sono dei punti dove i batteri si annidano senza che ne sai nulla. Cosa sta succedendo?
Il telecomando è uno degli oggetti più contaminati in casa. Ignorato durante le pulizie, accumula batteri come stafilococchi e coliformi. Un passaggio con alcool isopropilico può ridurre la carica batterica in pochi secondi.
Le cuffie auricolari ospitano batteri che proliferano con umidità e calore. L’uso prolungato favorisce la formazione di biofilm. Pulire cuffie auricolari con soluzioni delicate evita le infezioni e assicura un corretto funzionamento.
Il volante dell’auto è un altro punto critico. Tra spostamenti, snack e mani non sempre pulite, si accumulano batteri fecali e lieviti. Igienizzare il volante dell’auto con salviette antibatteriche è una pratica consigliata per chi condivide il veicolo. La contaminazione può superare quella di un bagno pubblico.
Anche le borse trattengono batteri per giorni. Il fondo della borsa, appoggiato ovunque, è il punto più critico. Lavare le borse in lavatrice o con prodotti specifici è utile per ridurre il rischio. Dove c’è la più alta concentrazione di batteri?
Dove restano i batteri
Le tastiere dei computer condivise sono tra gli oggetti più contaminati in ufficio. Tra le fessure si annidano batteri, muffe e residui organici. Igienizzare tastiera PC con aria compressa e spray antibatterici è una pratica consigliata in ambienti open space. Igienizza gli smartphone con panni in microfibra e soluzioni a base di alcool.
Combattere i batteri nelle tastiere garantisce la salute degli occhi e della pelle, dato che ci si tocca il viso dopo aver digitato. In contesti professionali, una tastiera pulita è anche segno di rispetto verso colleghi e collaboratori. L’igiene digitale non è solo estetica: è prevenzione.
Il caso
In una foto pubblicata come post sul profilo Instagram @effecore lo scorso 20 settembre, la didascalia riporta: “A volte la palestra può sembrare pulita ma la verità è che gli attrezzi che usiamo ogni giorno possono nascondere oltre un milione di germi per pollice quadrato…“. La didascalia continua: “… con i pesi liberi che contengono 362 volte più batteri di un sedile del WC, i tapis roulant 74 volte più di un rubinetto pubblico, e le cyclette 39 volte più di un vassoio da mensa. (Studio FitRated)“.
Come evitare le contaminazioni? “Pulire gli attrezzi prima e dopo l’uso, lavarsi le mani, non toccarsi il viso, cambiare gli abiti appena finito l’allenamento sono piccoli gesti che fanno una grande differenza” spiega la nota. In Italia la legge obbliga i gestori a tenere gli ambienti puliti e a procedere con una sanificazione periodica. L’igienizzazione dipende dall’attività e i protocolli sono rigidi: il rischio è di dover chiudere l’attività se non si rispettano le regole.
